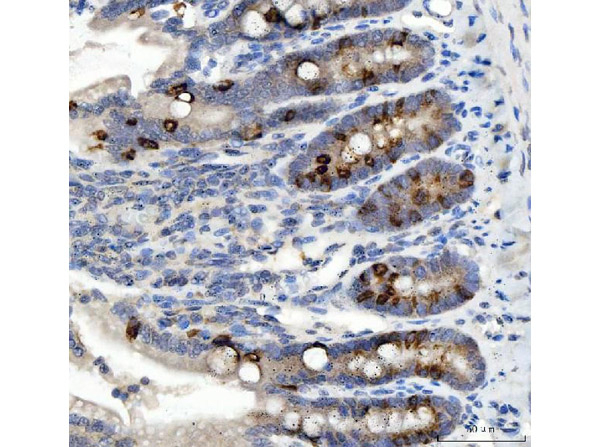
Nox1 Antibody in Immunohistochemistry (Paraffin) (IHC (P))

Search
Rockland
Nox1 Polyclonal Antibody
{{$productOrderCtrl.translations['antibody.pdp.commerceCard.promotion.promotions']}}
{{$productOrderCtrl.translations['antibody.pdp.commerceCard.promotion.viewpromo']}}
{{$productOrderCtrl.translations['antibody.pdp.commerceCard.promotion.promocode']}}: {{promo.promoCode}} {{promo.promoTitle}} {{promo.promoDescription}}. {{$productOrderCtrl.translations['antibody.pdp.commerceCard.promotion.learnmore']}}
FIGURE: 1 / 2
Nox1 Antibody (600-401-R15) in IHC (P)


Please note: We are reviewing Western blot images included in the antibody testing data in our catalog, including those provided by third parties. Unless expressly labeled or annotated as “raw-unedited”, Western blot images included in the antibody testing data in our catalog may have been edited, optimized or otherwise adjusted for presentation.
Product Details
600-401-R15
Species Reactivity
Host/Isotype
Class
Type
Immunogen
Conjugate
Form
Concentration
Amount
Purification
Storage buffer
Contains
Storage conditions
Shipping conditions
Target Information
Voltage-gated proton (hydrogen) channels play an important role in cellular defense against acidic stress. NOX1 is a homolog of the catalytic subunit of the superoxide-generating NADPH oxidase of phagocytes, gp91phox. Three splice variants of NOX1 have been identified, NOH-1L, NOH-1S and NOH-1Lv. NOH-1S is a voltage-gated proton channel that participates in the regulation of cellular pH and is blocked by zinc. NOH-1L is a pyridine nucleotide-dependent oxidoreductase that generates superoxide and might conduct H (+) ions as part of its electron transport mechanism, whereas NOH-1S does not contain an electron transport chain. NOX1 have the potential to be effective treatments for a range of ischemic diseases.
⚠WARNING: This product can expose you to chemicals including mercury, which is known to the State of California to cause birth defects or other reproductive harm. For more information go to www.P65Warnings.ca.gov.
For Research Use Only. Not for use in diagnostic procedures. Not for resale without express authorization.
References (0)
Bioinformatics
Protein Aliases: GP91 phox homolog; Mitogenic oxidase 1; MOX-1; MOX1; NADH/NADPH mitogenic oxidase subunit P65-MOX; NADPH oxidase 1; NADPH oxidase 1 alpha; NOH-1; NOX-1
Gene Aliases: GP91-2; MOX1; NOH-1; NOH1; Nox-1; Nox1; NOX1a; NOX1alpha
UniProt ID: (Rat) Q9WV87, (Mouse) Q8CIZ9
Entrez Gene ID: (Rat) 114243, (Mouse) 237038

Performance Guarantee
If an Invitrogen™ antibody doesn't perform as described on our website or datasheet,we'll replace the product at no cost to you, or provide you with a credit for a future purchase.*
Learn more
We're here to help
Get expert recommendations for common problems or connect directly with an on staff expert for technical assistance related to applications, equipment and general product use.
Contact tech support